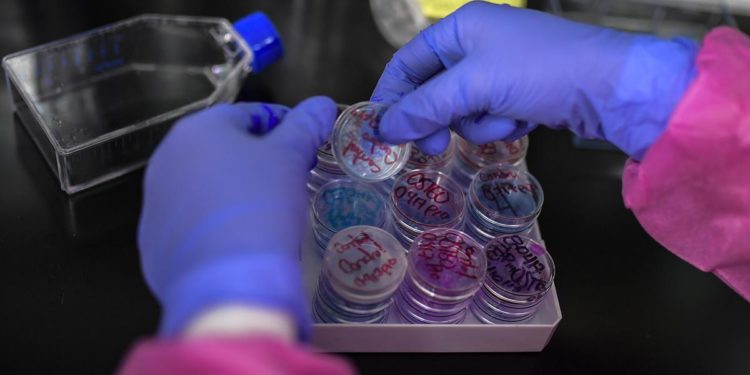
Covid oggi Abruzzo, 44 nuovi contagi: bollettino 5 giugno

Sono 44 i nuovi contagi da Coronavirus in Abruzzo secondo il bollettino di oggi, 5 giugno. Nessuna vittima da ieri. I guariti o dimessi sono stati 73 nelle ultime 24 ore. Tra le province con maggior contagi L’Aquila a 23 e Chieti a 12.
Covid oggi Abruzzo, 44 nuovi contagi: bollettino 5 giugno
0
Condivisioni
5
Visualizzazioni
Redazione Ultimenews24.it
Ultimenews24.it è un portale di news dove ti tiene informato sulle notizie su attualità, economia, salute, sport e alto ancora.
Ti potrebbero interessare i seguenti Articoli
Cerca Nel Sito
No Result
View All Result
Pubblicità

Ultimi Articoli

E’ un portale di news ai sensi del D.L. 7/5/2001 n. 62
Network
Informazioni
Contatti
Per parlare con la redazione: redazione@gmgmediacompany.it
Per la tua pubblicità: info@gmgmediacompany.it
© 2026 GMG Media Company Di Mossutti Gianluca | Sede legale: Corso Umberto Maddalena 25 - Cap 83030 - Venticano (AV) | P.IVA: 03234710642 | C.F: MSSGLC89D15L483O | REA: AV - 313130 | Domicilio digitale: gmgmediacompany@pec.it